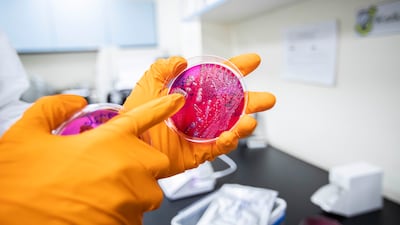
A laboratory technician at the Abu Dhabi Quality and Conformity Council shows cultures growing in a petri dish.

A team of scientists at a laboratory in Abu Dhabi are working tirelessly behind the scenes, testing hundreds of thousands of samples from the Emirate.
From groundwater to fresh produce and sanitary towels to hand sanitisers, the team at the Abu Dhabi Quality and Conformity Council's (QCC) central laboratory are doing their bit to keep UAE residents safe.
Even food and drinks offered at events such as the Formula One Grand Prix and music concerts are tested on site to make sure they are safe for consumption.
“It is ultimately a collaborative effort,” Manal Al Hashemi, laboratory director, told The National.
laboratory director
“We are sent a list of specifications by local authorities such as the Abu Dhabi Agriculture and Food Safety authority and we do all the required tests,” she said.
The council has a gamut of testing services, including radiation and environmental testing, as well as sample testing for products including food and beverages, water, building and construction materials, medicines and medical devices and cosmetics.
Samples are taken by inspectors from outlets or from shipments coming through the various borders.
Depending on the specimens, they are either stored and sent to the lab for testing, or tested on the spot.
Reports are then issued and sent to the relevant authorities for either distribution or confiscation, according to the results.
For years, the council has been working to raise the safety and quality standards of products traded in Abu Dhabi to safeguard consumer rights, support industry and protect the environment.

The QCC boasts one of the largest and most advanced testing laboratories in the country, using state-of-the- art equipment to tests thousands of samples that pass through the laboratory every day.
“When the Covid-19 pandemic started, we tested thousands of hand sanitisers,” said Ms Al Hashemi.
“Those that were found to be counterfeit or harmful were confiscated.
“Ultimately and in recent years, the market both locally and internationally knows how rigorous our testing procedures are so very few products or produce are found to be harmful.
“In the end, traders want to sell their products and make profit.
“I can’t recall a certain product or produce that had to be completely withdrawn from the market.
“Usually, like in the case of a product that had to be withdrawn a few years ago, it was only a specific batch.”
Ms Al Hashemi advises consumers to always read the labels and check expiry dates when buying goods.
“Our market is safe but there is never anything that is a hundred per cent or a zero chance of infection,” she said.
“As a consumer myself, I always check the labels.
“Oftentimes, and particularly during the summer months, it is necessary to check that milk products are stored in the proper temperatures.”
Labels are of particular importance if an individual has any allergies, she said.